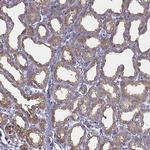
CEL Antibody in Immunohistochemistry (IHC)
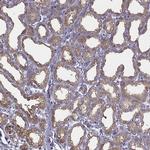
CEL Antibody in Immunohistochemistry (IHC)

Search
Invitrogen
CEL Polyclonal Antibody
{{$productOrderCtrl.translations['antibody.pdp.commerceCard.promotion.promotions']}}
{{$productOrderCtrl.translations['antibody.pdp.commerceCard.promotion.viewpromo']}}
{{$productOrderCtrl.translations['antibody.pdp.commerceCard.promotion.promocode']}}: {{promo.promoCode}} {{promo.promoTitle}} {{promo.promoDescription}}. {{$productOrderCtrl.translations['antibody.pdp.commerceCard.promotion.learnmore']}}

Please note: We are reviewing Western blot images included in the antibody testing data in our catalog, including those provided by third parties. Unless expressly labeled or annotated as “raw-unedited”, Western blot images included in the antibody testing data in our catalog may have been edited, optimized or otherwise adjusted for presentation.
产品信息
PA5-62668
种属反应
宿主/亚型
分类
类型
抗原
偶联物
形式
浓度
规格
纯化类型
保存液
内含物
保存条件
运输条件
RRID
产品详细信息
Immunogen sequence: LEYPMLHYVG FVPVIDGDFI PADPINLYAN AADIDYIAGT NNMDGHIFAS IDMPAINKGN KKVTEEDFYK LVSEFTITKG LRGAKTTFDV YTESWAQDPS QENKKKTVVD FETDVLFLVP TEIALAQH
Highest antigen sequence identity to the following orthologs: Mouse - 76%, Rat - 72%.
靶标信息
Caboxyl Ester Lipase (CEL), also known as Bile Salt-Activated Lipase, catalyzes the hydrolysis of a wide range of substrates including cholesteryl esters, phospholipids, lysophospholipids, di- and tri-acylglycerols, and fatty acid esters of hydroxy fatty acids (FAHFAs). Preferentially hydrolyzes FAHFAs with the ester bond further away from the carboxylate. Unsaturated FAHFAs are hydrolyzed more quickly than saturated FAHFAs. It also has an essential role in the complete digestion of dietary lipids and their intestinal absorption, along with the absorption of fat-soluble vitamins. [UniProt]
仅用于科研。不用于诊断过程。未经明确授权不得转售。
篇参考文献 (0)
生物信息学
蛋白别名: BAL; Bile salt-activated lipase; Bile salt-stimulated lipase; BSSL; Bucelipase; Carboxyl ester lipase; Cholesterol esterase; Pancreatic lysophospholipase; Sterol esterase
基因别名: BAL; CEL
Entrez Gene ID: (Human) 1056




